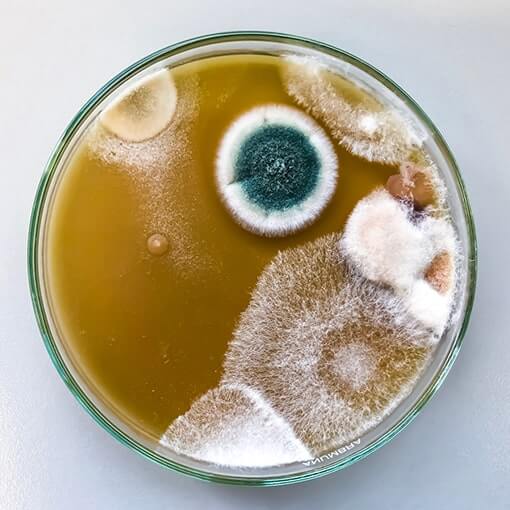
Schimmel-Selbsttest-Raumluft

Lieferzeit 1-3 Werktage
Schimmel-Selbsttest-Raumluft ist auf Lager und wird versandt, sobald es wieder verfügbar ist
Verfügbarkeit für Abholungen konnte nicht geladen werden
Einzeln
29,00 € / Stück
ab 3 Stck.
Das könnte Sie auch interessieren:
Hinweise
Hinweise
Produktsicherheit
Produktsicherheit

Produktdetails
Schimmel schnell erkennen - der Bestseller unserer Schimmeltests
Sie sind auf der Suche nach einem preiswerten Schimmeltest zum Selbstauswerten? Im Test-Set ist alles, was Sie für eine orientierende Untersuchung eines möglichen Schimmelbefalls benötigen. Neben einer vakuumierten Sedimentationsplatte erhalten Sie den IVARIO-Schimmelratgeber, um die Probe kinderleicht selbst auszuwerten. Der Ratgeber zeigt Ihnen an bildhaften Beispielen, wie stark Ihre Raumluft belastet ist.
Sollten Sie eine hohe oder sehr hohe Belastung feststellen, empfiehlt sich eine anschließende Laboranalyse, um die Schimmelart* und mögliche Ursachen für den Schimmelbefall feststellen zu lassen. Bei bereits sichtbarem Schimmel empfehlen wir Ihnen sofort eine Laboranalyse zu bestellen, da Selbsttests/Schnelltests für gesundheitliche Rückschlüsse nicht genügend Aussagekraft haben. Für eine erste Einschätzung der Situation hingegen eignet sich der Selbsttest sehr gut.
Lieferumfang:
- Probenahme-Set mit vakuumierter Sedimentationsplatte
- IVARIO-Schimmelratgeber
- Anleitung
Achtung: Die Sedimentationsplatte innerhalb eines Monates nach Erhalt nutzen, da sonst die Nährlösung austrocknet.
Wichtiger Hinweis: Bitte wählen Sie über das "Mengenfeld" die gewünschte Anzahl an Räumen aus, die Sie testen möchten. Es empfiehlt sich Schlaf-, Wohn- und Kinderzimmer (falls vorhanden) zu testen.
*Per Definition wird in unseren Analysen eine Schimmelgattung bestimmt, keine Schimmelart. Allerdings werden beide Begriffe im allgemeinen Sprachgebrauch oft synonymisch verwendet, weshalb in diesem Artikel auch der Begriff Schimmelart Verwendung findet.





Warum eine Analyse durchführen?